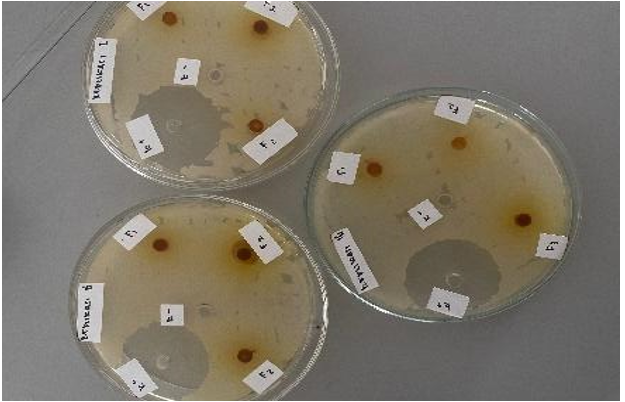

Department of Pharmaceutics, Faculty of Pharmacy, Universitas Muhammadiyah Banjarmasin, Gubernur Syarkawi, Barito Kuala, Kalimantan Selatan, Indonesia
*Corresponding author: Risa Ahdyani; *Email: risaahdyani@umbjm.ac.id
Received: 10 Jan 2024, Revised and Accepted: 28 Mar 2025
ABSTRACT
Objective: This study aimed to formulate and evaluate the antibacterial activity of a nanogel preparation incorporating Bangkal (Nauclea subdita) bark extract against Propionibacterium acnes.
Methods: Bangkal bark extract was obtained using a maceration technique with 70% ethanol as the solvent (1:10). The resulting thick extract was then formulated into a nanogel and subjected to stability testing. Antibacterial activity was assessed using the well diffusion method. The nanogel formulation exhibiting the highest inhibition zone underwent particle size analysis using a Particle Size Analyzer (PSA). Bangkal bark was extracted using a maceration technique with 70% ethanol solvent (1:10). The thick extract obtained was then made into nanogels, stability tests were carried out, and its antibacterial activity was tested using the well method. The nanogel with the highest inhibition zone will have its particle size identified using a Particle Size Analyzer (PSA).
Results: The Bangkal bark extract nanogel was successfully formulated as a homogenous, thick brown gel with a characteristic extract aroma. PSA analysis revealed a nanoparticle size of 0.995 nm. The antibacterial assay showed effective inhibition of P. acnes, with inhibition zones ranging from 6 to 8 mm. The F3 formulation (8% extract) exhibited the highest antibacterial activity with an 8 mm inhibition zone.
Conclusion: This study demonstrates the potential of Bangkal bark extracts in a nanogel formulation for acne treatment. The F3 formulation (8% extract) showed moderate antibacterial activity, suggesting its viability as a natural alternative for acne management. Ethanol as a green solvent supports sustainable and eco-friendly formulation development.
Keywords: Acne vulgaris, Bangkal bark extract (Nauclea subdita), Nanoparticle gel, Propionibacterium acnes bacteria
© 2025 The Authors. Published by Innovare Academic Sciences Pvt Ltd. This is an open access article under the CC BY license (https://creativecommons.org/licenses/by/4.0/)
DOI: https://dx.doi.org/10.22159/ijap.2025v17i3.53657 Journal homepage: https://innovareacademics.in/journals/index.php/ijap
Acne vulgaris is a common chronic skin condition, especially in adolescents, characterized by inflammation of the hair follicles and sebaceous glands that produce excess sebum. According to data, around 85% of young adults aged 12-25 y experience this condition. In Indonesia, the prevalence of acne vulgaris increased from 60% in 2006 to 90% in 2009 [1]. Internal factors such as increased sebum production, hyperkeratinization of hair follicles, colonization of Propionibacterium acnes bacteria, and inflammation play an important role in the pathogenesis of acne vulgaris. P. acnes is a bacterium naturally present on human skin but can cause inflammation when its population increases. It produces lipase enzymes that hydrolyze sebum into free fatty acids, triggering an inflammatory response and attracting immune cells to fight infection [2]. In addition, P. acnes produces other factors that contribute to the formation of blackheads and inflammatory lesions, such as biofilms that clog pores. Although the exact mechanism of acne development is not fully understood, hormonal factors and psychological stress are also thought to play a role in exacerbating the condition [3].
One plant with potential as an anti-acne agent is Bangkal bark (Nauclea subdita), which grows in wetlands such as swamps and river banks. The bark of Bangkal is known to contain various bioactive compounds, including flavonoids, terpenoids, alkaloids, phytosterols, saponins, and phenolic compounds. Flavonoids are known to have significant antibacterial and antioxidant activities, which can inhibit the growth of P. acnes and reduce skin inflammation. In addition, alkaloids such as subditine isolated from Bangkal bark showed cytotoxic activity against prostate cancer cells, suggesting potential for broad bioactivity [4]. However, further research is needed to understand these compounds' mechanism of action and therapeutic potential in treating acne vulgaris.

Fig. 1: Bangkal plant (Nauclea subdita) from South Kalimantan
Nauclea subdita is traditionally found in wet soils such as swamps and riverbanks. Phytochemical studies have revealed that Bangkal bark contains significant amounts of flavonoids, terpenoids, alkaloids, phytosterols, saponins, and phenolic compounds. These compounds are known for their antioxidant and antibacterial properties [5]. The flavonoid content has been quantified at approximately 44.728 mg quercetin equivalents per g of extract. The presence of these bioactive compounds suggests potential therapeutic applications, particularly in dermatology. Recent studies have demonstrated the antibacterial efficacy of Bangkal bark extract against P. acnes [6]. For instance, an ethanol extract of Bangkal leaves exhibited significant antibacterial activity against P. acnes, with an inhibition zone measuring 8.56 mm at an 80% concentration. These findings indicate that Bangkal extract could serve as a natural alternative in acne treatment, targeting the bacterial component of acne pathogenesis [7].
Incorporating Bangkal bark extract into nanogel formulations offers several advantages for topical application. Nanogel formulations present significant advantages for topical applications, particularly in enhancing the delivery of active compounds such as Bangkal bark extract. As three-dimensional cross-linked polymer networks on the nanometer scale, nanogels exhibit a high surface area to volume ratio, which not only increases drug loading capacity but also enhances stability by protecting bioactive compounds from degradation. Their nanoscale size facilitates deeper penetration into the skin layers, allowing for efficient and localized drug delivery [8]. This characteristic is especially beneficial for dermatological applications, where targeted action at specific skin layers is crucial for therapeutic efficacy [9]. Additionally, nanogels can be engineered to provide controlled and sustained release of active ingredients, reducing the need for frequent application and thereby improving patient compliance as for nanogels also have the ability to modulate drug release also minimizes potential side effects, as it prevents excessive exposure to the active compound in a short period [9].
From a green chemistry perspective, incorporating Bangkal bark extract into nanogels aligns with sustainable pharmaceutical and cosmetic formulations. Bangkal bark extract, derived from natural sources, offers an eco-friendly alternative to synthetic active ingredients, reducing reliance on chemical additives that may have environmental consequences. The use of biodegradable and biocompatible polymers such as chitosan and alginate in nanogel preparation further enhances sustainability [10]. These natural polymers are derived from renewable resources and can degrade safely without leaving harmful residues, making them environmentally friendly carriers for active compounds [11]. By integrating these principles, nanogel formulations incorporating Bangkal bark extract represent a promising advancement in environmentally conscious skincare and pharmaceutical development.
This study aims to formulate a nanogel containing Bangkal bark extract and evaluate its antibacterial activity against P. acnes. By leveraging the unique properties of both the extract and the nanogel delivery system, this research seeks to develop an effective and natural topical treatment for acne vulgaris.
Materials
The tools used in this study were a collection of glassware (Pyrex), digital scales (Ohaus PA214), a mechanical stirrer (IKA RW 20 digital), a hot plate (Maspion S-301), an oven (Memmert UNB 400), a pulverizer, a set of spreadability test tools, adhesive power, a pH meter (Lutron PH-208), a magnetic stirrer (Nesco H280 Pro), an ultra turrax (IKA T25 digital), a viscometer (Brookfield DV2T), a petri dish (Pyrex), an Erlenmeyer (Pyrex), an autoclave (Plus Timer YX 280 D), aluminum foil, a caliper, and an incubator (Memmert). The main ingredients are oven-dried Bangkal bark, which is obtained from Hulu Sungai Selatan Regency, especially the Kandangan area; chitosan; sodium alginate; calcium chloride; glycerin; propylene glycol; sodium metabisulfite; hydroxypropyl methylcellulose (HPMC); fragrance; distilled water; Propionibacterium acnes bacterial culture; and nutrient agar (NA).
Research procedures
Bangkal bark collection (Nauclea subdita)
The Bangkal (Nauclea subdita) bark used in this study was collected from Hulu Sungai Selatan, South Kalimantan, Indonesia (Geographical coordinates: approximately 2° 45' 0" S latitude and 115° 12' 0" E longitude). The plant material was identified and authenticated at UPTD Kebun Raya Banua, Provincial Government of South Kalimantan, through a taxonomic determination process to confirm its botanical identity. The specimen was assigned voucher number 000/0169-LIT/KRB/2025 for reference. This determination ensured the plant species' accuracy in this research, aligning with its taxonomic classification.
Bangkal bark (Nauclea subdita) Extraction
The ethanol extract was obtained using the maceration method with 70% ethanol solvent in a 1:10 ratio. The maceration process was done by soaking the simplisia in 70% ethanol for 3 days. In the first 6 h, the solution was stirred periodically every 5 min to increase extraction efficiency. This process was repeated up to three times to ensure optimal extraction of bioactive compounds [12].
The type of ethanol used in this process is analytical grade ethanol, which has a high purity level and is free from contaminants that can affect the extraction results [13]. The choice of 70% ethanol as a solvent is based on its polarity balance, which allows for more effective extraction of polar and semi-polar compounds from Bangkal stem bark than ethanol with higher or lower concentrations. 70% ethanol is also widely used to extract bioactive compounds due to its ability to penetrate cell walls and dissolve secondary metabolites such as alkaloids, flavonoids, and tannins [14].
After the maceration process, the solution was extracted and filtered to obtain the filtrate. The remaining dregs were then re-macerated twice to ensure maximum extract yield. All macerated filtrates were combined and concentrated with a rotary evaporator at 40-50 °C to remove the ethanol solvent without damaging the bioactive compounds. After that, the extract was thickened using a water bath until a thick extract was obtained [12].
Formulation of nanogel preparation of bangkal bark extract (Nauclea subdita)
Previous studies have proven that bark extract effectively stops the growth of P. acnes bacteria. Therefore, nanogel formulations with 6%, 7%, and 8% concentrations were chosen to study the impact of the extract on its antibacterial activity. The purpose of concentration variation is to ensure that the extract remains effective and to reveal the relationship between the concentration of the extract and the resulting antibacterial activity [15]. It is aimed that formulations with varying concentrations will find the ideal zone of inhibition, indicating the ability of the extract to stop the development of acne-causing bacteria.
Table 1: Gel formulation of ethanol extract of Bangkal bark 6%, 7%, 8%
| Formulation | Function | Formulation (grams) |
| F 1 | ||
Bangkal Bark Extract Sodium Alginate Chitosan CaCl2 Glycerin Propylene Glycol Sodium Metabisulfite HPMC Fragrance |
Active Substance Bioactive Polymer Polymer Polymer Humectant Humectant Preservative Gelling agent Fragrance |
6 0.1 1 2.5 15 15 0.1 1 5 gtt |
| Aquadest | Solvent | Add 100 ml |
Information: F1: Concentration of 6%, F2:Concentration of 7%, F3: Concentration of 8%
Preparation of nanogel preparations
The stem bark extract was formulated into a nanogel dosage form, with extract concentrations of 6%, 7%, and 8% in each formula, as presented in table 1. The preparation began with the dissolution of 1 g of Hydroxypropyl Methylcellulose (HPMC) in 50 ml of distilled water at 70 °C, which was then set aside. Separately, sodium metabisulphite was dissolved in glycerin and stirred until homogeneous. In another beaker, the extract was combined with 10 ml of chitosan, calcium chloride, and sodium alginate and stirred using a magnetic stirrer at 500 rpm for 5 min. Subsequently, the glycerin and propylene glycol solution was added to this mixture and stirred at 500 rpm for another 5 min [16].
The selection of chitosan and sodium alginate in the polymer blend is based on their complementary properties. Chitosan, a biocompatible and biodegradable natural polymer, enhances the viscosity and stability of nanogels and can bind bioactive molecules, which is beneficial in pharmaceutical and cosmetic applications. Additionally, chitosan imparts antibacterial and anti-inflammatory properties to the nanogels, increasing their application potential. Sodium alginate, derived from brown algae, acts as a thickener that helps form a stable gel structure [17]. When combined, the interaction between these two polymers results in nanogels with desirable characteristics, such as mechanical strength and controlled release ability. The optimization of their concentrations is crucial to achieve a balance between gel strength and flexibility, ensuring the nanogel's efficacy and stability. Studies have shown that varying the ratios of chitosan to sodium alginate can significantly influence the active compounds' encapsulation efficiency and release profiles [18].
The choice of a 2% w/v concentration of HPMC as the thickening agent is justified by its ability to provide the desired viscosity and gel consistency. HPMC is widely used in topical formulations due to its non-ionic nature, biocompatibility, and ease of use. At this concentration, HPMC effectively increases the formulation's viscosity, ensuring appropriate gel consistency and stability. This concentration has been found to balance ease of application and retention on the skin or mucosal surfaces [19].
The mechanical stirring parameters were optimized to ensure uniform mixing and nanoparticle formation. An initial stirring speed of 500 rpm for 5 min was employed to properly distribute chitosan, calcium chloride, and sodium alginate with the extract. This speed ensures adequate shear force to break down agglomerates and promotes uniform distribution of components. Subsequently, adding the glycerin and propylene glycol solution, followed by stirring at the same speed for another 5 min, ensures thorough mixing and homogenization [20]. Finally, the gradual incorporation of the HPMC solution, with continuous stirring at 500 rpm for 1 hour, allows for the development of the desired gel structure and consistency. These parameters were selected based on preliminary trials to achieve a homogenous nanogel with optimal physicochemical properties. After the final mixing, five drops of fragrance were added, and distilled water was added to bring the total volume to 100 ml. The mixture was then stirred until homogeneous, resulting in the final nanogel formulation, as depicted in fig. 2 below.

Fig. 2: Illustration of formulating nanogel from bangkal bark extract
Evaluation of nanogel preparations of bangkal bark extract (Nauclea subdita)
The organoleptic examination
The organoleptic valuation was conducted to assess the gel preparation's physical characteristics, including texture, color, and aroma. This test was conducted visually and sensorially to ensure the gel's conformity with the expected quality standards [21].
Texture
Observed directly by touching the gel to assess its softness, homogeneity, and consistency.
Color
Visually inspected to ensure the color of the gel matches the desired formulation and is stable during storage.
Aroma
The intensity of aroma was evaluated using a subjective approach through a sensory test panel. The aroma of Bangkal bark extract in the nanogels was observed based on its intensity level, i. e., weak, medium, or firm. Panelists rated the aroma characteristics using a specific intensity scale to determine whether the aroma produced aligned with the expected formulation.
Test of homogeneity
One g of gel preparation is taken from the middle, bottom, left, and right sides to perform the homogeneity test. It is then applied to a glass object to check for particles and areas not thoroughly mixed [22].
Test of spreadability
500 mg of the gel preparation was weighed and then placed on a 15 cm round glass to conduct the spreadability test. A second round glass was then placed on top of it, and after a minute, the gel spread diameter was measured. Adding loads of 50 g, 100 g, 150 g, and 200 g allowed for measuring the gel spread diameter. The gel spread diameter was measured as before after each extra load was left for one minute [23].
Test of adhesion
A second glass is placed over the 500 mg of gel preparation and positioned in the middle of the bottom glass area. A 200 g load is put in for two minutes. The time it takes for the two attached glasses to separate is then measured using an adhesion tester [23].
Test of pH
It was carried out using a pH meter to determine the gel's pH value. After dipping the tool's tip into the preparation solution, the tool displays a stable pH value [24].
Test of viscosity
The gel was weighed as much as 100 g and transferred into a beaker. Viscosity testing was carried out using a Brookfield LV Viscometer at a speed of 30 rpm for 5 min using spindle no. 3. The viscosity value (cPs) indicated on the Brookfield LV Viscometer is the viscosity value of the preparation with the viscosity specifications of the gel preparation ranging from 4.000-40.000 cP [24].
Test of stability
The stability of a gel preparation is a critical parameter in determining the product's quality, effectiveness, and safety during storage. Accelerated stability testing is conducted to simulate extreme environmental conditions to estimate the stability of the product over a shorter period than long-term stability testing. This study used extreme temperature cycles to perform the accelerated stability test method. One cycle consisted of storing the gel at a low temperature (4 °C) for 24 h, followed by storage at a high temperature (40 °C) for 24 h. This test was conducted in three consecutive cycles to evaluate the physical and chemical resistance of the gel preparation [25]
Antimicrobial properties test of nanogel preparation using bangkal bark extract against p. acnes bacteria
This antibacterial activity test was carried out using the well method. The sound method is executed by making perpendicular holes in the solid agar inoculated with the test bacteria. The holes are filled with the samples to be tested after their quantity and placement are modified by the study's goals. Following that, incubation was conducted for 24 h at 37 °C. Bacterial growth was stopped by determining whether or not there was an inhibition area surrounding the hole [26]. The antimicrobial inhibition zone's activity is divided into four groups: weak activity (less than 5 mm), moderate activity (5–10 mm), vigorous activity (10–20 mm), and extreme activity (more than 20 mm). Using a vernier caliper, draw a horizontal line in the precise area surrounding the well to determine the inhibition zone [27].
The P. acnes bacteria used in this study were obtained from Muhammadiyah Banjarmasin University Microbiology Laboratory. The specific strain code for P. acnes for research purposes is commonly identified as ATCC 6919. This bacterium was selected due to its significant role as a primary causative agent of acne, with a higher prevalence than other bacterial species associated with skin conditions.
The first was the homogeneity and organoleptic test, which assessed the preparation's color, shape, homogeneity, and odor. Tables 2 and 3 display the outcomes of the homogeneity and organoleptic tests. The homogeneity test of the Bangkal bark extract (Nauclea subdita) Nanogel preparation at concentrations of 6%, 7%, and 8% in the treatment prior to and following the stability test is examined in table 2. The homogeneity test results demonstrated the homogeneous gel preparation. An even color equation on each nanogel preparation indicated that no particle spots were visible when the preparation was placed on transparent glass. Findings from the homogeneity test of the Bangkal bark extract nanogel preparation before and after the stability test.
Table 2: Observation results of the bangkal bark extract nanogel preparation homogeneity test before and after stability testing
| Before stability test | ||
| Formula | Replication | Homogeneity |
| F1 | R1 | Homogenous |
| R2 | Homogenous | |
| R3 | Homogenous | |
| F2 | R1 | Homogenous |
| R2 | Homogenous | |
| R3 | Homogenous | |
| F3 | R1 | Homogenous |
| R2 | Homogenous | |
| R3 | Homogenous | |
| After Stability Test | ||
| F1 | R1 | Homogenous |
| R2 | Homogenous | |
| R3 | Homogenous | |
| F2 | R1 | Homogenous |
| R2 | Homogenous | |
| R3 | Homogenous | |
| F3 | R1 | Homogenous |
| R2 | Homogenous | |
| R3 | Homogenous | |
*n = 3 replications (R1, R2, R3); F1 = Bangkal bark extract 6%; F2 = Bangkal bark extract 7%; F3 = Bangkal bark Extract 8%
When applied to transparent glass, the homogeneity test results revealed that none of the Nanogel preparations displayed any coarse grains, proving that the preparation was homogeneous. In the second test, namely the organoleptic test, the results of the observations revealed that the Nanogel preparation had a thick, semi-solid form both before and after the stability test, as seen in the picture below.
Based on observations of the aroma produced by the three formulations that have been made, Formula 1 has a weak Bangkal wood aroma, Formula 2 has a moderate Bangkal bark aroma, and Formula 3 has a more pungent Bangkal bark aroma; the higher the concentration of Bangkal bark extract in the preparation, the more pungent the aroma produced. Table 3 indicates that the color of the resulting Nanogel preparation will be more concentrated, specifically from brown to dark brown. In order to guarantee formulation stability and reduce the possibility of skin irritation, the third test is a pH test. Table 4 displays the test results.
The pH test results of the Bangkal bark extract nanogel demonstrated that before and after the stability test, the pH remained within the acceptable range of 4.5 to 6.5, complying with formulation specifications. The initial average pH was 5.27±0.06, which decreased slightly to 5.06±0.04 after the stability test. Despite this minor reduction, the pH value still met stability standards, as indicated by a p-value of 0.285, signifying an insignificant change. Previous studies have reported that gallic acid and other secondary metabolites in Bangkal bark extract play a role in regulating pH [12]. Research on other herbal antimicrobials, such as green tea polyphenols, has shown that acidic secondary metabolites can influence pH stability in formulations [28]. These findings reinforce the hypothesis that the secondary metabolites in Bangkal bark extract contribute to the slight pH decrease observed in the nanogel preparation.
The fourth test is the spreadability test, which aims to evaluate the ability of a formulation to spread evenly on the skin surface after being applied. The test results can be seen in table 5 below:

Fig. 3: Homogeneity and organoleptic
Table 3: Observation results of the Bangkal bark extract nanogel preparation organoleptic test before and after stability testing
| Before stability test | ||||
| Formula | Replication | Color | Smell | Shape |
| F1 | R1 | Brown | Smell of Bangkal | Semi solid |
| R2 | Brown | Smell of Bangkal | Semi solid | |
| R3 | Brown | Smell of Bangkal | Semi solid | |
| F2 | R1 | Brown | Smell of Bangkal | Semi solid |
| R2 | Brown | Smell of Bangkal | Semi solid | |
| R3 | Brown | Smell of Bangkal | Semi solid | |
| F3 | R1 | Dark Brown | Smell of Bangkal | Semi solid |
| R2 | Dark Brown | Smell of Bangkal | Semi solid | |
| R3 | Dark Brown | smell of Bangkal | Semi solid | |
| After stability test | ||||
| F1 | R1 | Brown | Smell of Bangkal | Semi solid |
| R2 | Brown | Smell of Bangkal | Semi solid | |
| R3 | Brown | Smell of Bangkal | Semi solid | |
| F2 | R1 | Brown | Smell of Bangkal | Semi solid |
| R2 | Brown | Smell of Bangkal | Semi solid | |
| R3 | Brown | Smell of Bangkal | Semi solid | |
| F3 | R1 | Dark Brown | Smell of Bangkal | Semi solid |
| R2 | Dark Brown | Smell of Bangkal | Semi solid | |
| R3 | Dark Brown | Smell of Bangkal | Semi solid | |
*n = 3 replications (R1, R2, R3); F1 = Bangkal bark extract 6%; F2 = Bangkal bark extract 7%; F3 = Bangkal Bark Extract 8%
Table 4: Findings from the pH test observations of the bangkal bark extract nanogel preparation prior to and following the stability test
| Formula | Before test | After test | Requirements (4.5 – 6.5) | P – value (sig) |
| Results±SD | Results±SD | |||
| F1 | 5.37±0.01 | 4.77±0.58 | Qualify | 0.260 |
| F2 | 5.23±0.06 | 4.64±0.58 | Qualify | |
| F3 | 5.10±0.00 | 5.26±0.02 | Qualify |
*n = 3 replications for each formulation (F1, F2, and F3); F1 = Bangkal bark extract 6%; F2 = Bangkal bark extract 7%; F3 = Bangkal Bark Extract 8%
Table 5: Observation results of the spreadability test of Bangkal Bark Extract nanogel preparations before and after stability testing
| Formula | Before test | After test | Requirements (5-7 cm) |
P – value (sig) |
| Results±SD | Results±SD | |||
| F1 | 5.83±0.57 | 5.83±0.57 | Qualify | 0.414 |
| F2 | 6.16±0.28 | 5.83±0.76 | Qualify | |
| F3 | 5.5±0.5 | 6.16±0.28 | Qualify |
*n = 3 replications for each formulation (F1, F2, and F3); F1 = Bangkal bark extract 6%; F2 = Bangkal bark extract 7%; F3 = Bangkal Bark Extract 8%
The spreadability test results in the table above indicate that all formulations achieved a spreadability range of 5–7 cm. Before the stability test, formulations F1, F2, and F3 had spreadabilities of 5.83±0.57 cm, 6.16±0.28 cm, and 5.5±0.5 cm, respectively. After the test, formulation F1 remained stable at 5.83±0.57 cm, F2 slightly decreased to 5.83±0.76 cm, and F3 increased to 6.00 cm. Spreadability is influenced by viscosity and interactions among formulation components. The statistical analysis (p-value = 0.414) confirmed no significant difference before and after the stability test. Good spreadability ensures uniform drug application on the skin, enhancing therapeutic effectiveness. The slight decrease in F2's spreadability suggests possible changes in viscosity, whereas the increase in F3's spreadability may indicate improved stability over time. These results align with previous studies, emphasizing that formulation stability directly impacts the effectiveness of topical applications [29].
According to the literature, the adhesion test, the fifth test, is crucial to ensuring that the preparation stays in the intended spot and has the best possible effects on the skin. Table 6 below displays the test results.
Table 6: Results of the adhesion test conducted on the nanogel preparation of Bangkal bark extract before and following the stability test
| Formula | Before test | After test | Requirements (>4 second) |
P – value (sig) |
| Results±SD | Results±SD | |||
| F1 | 1.26±0.72 | 0.803±0.67 | Qualify | 0.414 |
| F2 | 0.63±0.45 | 0.44±0.12 | Qualify | |
| F3 | 0.71±0.38 | 0.86±0.32 | Qualify |
*n = 3 replications for each formulation (F1, F2, and F3); F1 = Bangkal bark extract 6%; F2 = Bangkal bark extract 7%; F3 = Bangkal Bark Extract 8%
The adhesion test revealed that all formulations exhibited adhesion times exceeding four seconds. Prior to the stability test, adhesion times were recorded as follows: F1 (1.26±0.72 s), F2 (0.63±0.45 s), and F3 (0.71±0.38 s). After the test, adhesion times for F1 and F2 decreased to 0.803±0.67 s and 0.44±0.12 s, respectively, whereas F3’s adhesion increased to 0.86±0.32 s. The p-value (>0.05) confirmed no significant difference in adhesion before and after the stability test. The increased adhesion in F3 suggests more excellent formulation stability, which aligns with studies indicating that stable formulations typically exhibit better adhesion properties [29].
The viscosity test, the sixth test, assesses a substance’s worth. The viscosity value increases with increasing viscosity. Table 7 displays the test results.
Table 7: Shows the findings from the viscosity test of the nanogel preparation made from Bangkal bark extract both before and after the stability test
| Formula | Before test | After test | Requirements (4.000-40.000 cPs) |
P – value (sig) |
| Results±SD | Results±SD | |||
| F1 | 6.144± 1124.26 | 5.478±978.92 | Qualify | 0.122 |
| F2 | 4.400±1980.51 | 3.161±804.36 | Not eligible | |
| F3 | 5.295±1298.96 | 5.278±157.46 | Qualify |
*n = 3 replications for each formulation (F1, F2, and F3); F1 = Bangkal bark extract 6%; F2 = Bangkal bark extract 7%; F3 = Bangkal Bark Extract 8%
The viscosity test results showed that formulations F1 and F3 met the required viscosity range of 4.000 to 40.000 cps. Before stability testing, formulation F1 had a viscosity of 6.144±1.124.26 cps, which decreased slightly to 5.478±978.92 cps after the test. Formulation F2 had an initial viscosity of 4.400±1.980.51 cps. Statistical analysis (p-value = 0.122) indicated no significant differences in viscosity before and after stability testing. Viscosity is crucial for ensuring effective skin absorption and retention of the drug. The reduction in F2’s viscosity suggests possible alterations in component interactions, whereas the stability in F1 and F3 indicates enhanced formulation robustness [29]. The study has demonstrated that maintaining viscosity stability is essential for improving drug efficacy and formulation consistency.
The seventh test is the inhibition activity test of P. Acnes bacteria using the healthy diffusion method. The results of the Nanogel test of Bangkal bark extract on P. Acnes bacteria show that there is a clear zone (inhibitory power) around the well on the MHA media that has been planted with bacteria.
Fig. 4: Antibacterial inhibition test
Table 8: Antibacterial inhibition test of Bangkal bark extract nanogel preparation before stability testing and after stability testing
| Formula | Antibacterial activity test | |
| Inhibition zone | Inhibition zone criteria | |
| K- | 0.00±0.00 | - |
| K+ | 29.00±1.52 | Very strong |
| F1 | 6.00±2.75 | Medium |
| F2 | 7.00±1.00 | Medium |
| F3 | 8.00±3.32 | Medium |
*K-= Aquadest; K+= Chloramphenicol 2%; F1 = Bangkal bark extract 6%; F2 = Bangkal bark extract 7%; F3 = Bangkal Bark Extract 8%
The antibacterial activity of the Bangkal bark extract nanogel against Propionibacterium acnes was assessed using the agar diffusion method. The results indicated the formation of inhibition zones ranging from 6 mm to 8 mm, signifying moderate antibacterial activity. At a concentration of 8%, the nanogel exhibited the highest antibacterial efficacy, whereas at 6%, it showed the lowest activity. These findings are consistent with prior studies on herbal antimicrobial agents, such as neem and turmeric extracts, exhibiting concentration-dependent antibacterial effects [30]. The one-way ANOVA analysis and the Shapiro-Wilk normality test confirmed that the data were normally distributed (F1 sig = 0.900, F2 sig = 1.000, F3 sig = 0.583). However, homogeneity analysis (Based on Mean) indicated non-homogeneous variance (sig<0.05), suggesting differences in formulation behavior.
The eighth test involves using a particle size analyzer (PSA) to determine the size of the particles in Bangkal bark extract.

Fig. 5: Graphic of a particle size analyzer (PSA) formulation 3
The analysis of the particle size of Bangkal bark extract using the Particle Size Analyzer (PSA) shows that the resulting nanogel has an average particle size of 0.995 nm. This small size is significant, especially in F3 (Formulation 3), with a concentration of 8%, which has been identified as one of the most effective formulations. Nanogel with a particle size on the nanometer scale from F3 (Formulation 3) can penetrate the skin layer well, increasing the penetration and effectiveness of the preparation. This contributes to increasing the antibacterial ability against P. Acnes bacteria, the leading cause of acne problems. Previous research by [29] found that Bangkal bark extract showed significant antibacterial activity, with an inhibition zone reaching 8±0.81 mm against P. Acnes. Thus, the results of these particle measurements strengthen the claim that Formulation 3 at a concentration of 8% is not only of high quality but also has the potential to be an effective alternative in treating acne.
Combining chitosan and alginate in nanogel formulations can significantly influence the delivery and efficacy of active compounds. Chitosan, a cationic polysaccharide, and alginate, an anionic polysaccharide, interact electrostatically to form polyelectrolyte complexes, which can encapsulate active compounds effectively. This interaction stabilizes the nanogel structure and facilitates the controlled release of the encapsulated agents. Previous studies have shown that chitosan-alginate-based hydrogels enhance the antibacterial activity of incorporated agents by providing a conducive environment for sustained release and leveraging the polymers' inherent antimicrobial properties [32]. For instance, research indicates that chitosan and alginate-based hydrogels can effectively deliver antibacterial agents, significantly inhibiting bacterial growth. Additionally, the combination of these biopolymers has been utilized to develop bioactive films with enhanced mechanical properties and antimicrobial efficacy, further supporting their role in modulating the performance of active compounds in various applications [33].
The 8% bank bark extract (Nauclea subdita) nanogel formulation (F3/Formulation 3) demonstrates significant antibacterial activity against Propionibacterium acnes, with an inhibition zone of up to 8 mm, classifying it as moderately effective. The nanogel exhibits desirable physical properties, including stability, homogeneity, and viscosity, making it a promising alternative anti-acne formulation. These findings highlight the potential of Nauclea subdita extract in dermatological applications. However, further research, such as in vivo studies and cytotoxicity evaluations, must confirm its efficacy and safety for clinical use.
We want to express our gratitude to Universitas Muhammadiyah Banjarmasin for the support and facilities of the Pharmacy Laboratory at the Faculty of Pharmacy, Universitas Muhammadiyah Banjarmasin, which allowed the research to run smoothly.
Nil
HJ has compiled the data and prepared the manuscript. DSY, A, NF, RA and RA designed the research, analyzed the data, and did critical thinking on the manuscript.
The author declares no conflict of interest.
Clarissa F, Gunawan D. The relationship between severity of acne vulgaris and psychosocial burden on students at atma jaya catholic university of Indonesia school of medicine and Health Sciences. Damianus J Med. 2019;18(2):74-9. doi: 10.25170/djm.v18i2.2223.
Legiawati L, Halim PA, Fitriani M, Hikmahrachim HG, Lim HW. Microbiomes in acne vulgaris and their susceptibility to antibiotics in Indonesia: a systematic review and meta-analysis. Antibiotics (Basel). 2023;12(1):145. doi: 10.3390/antibiotics12010145, PMID 36671346.
Aryawangsa IG, Angelica Vanini Winata T, Yumna N, Icha Aisyah. The relationship between diet and the incidence of acne vulgaris among preclinical medical students at medical faculty of Unizar. J Kedokteran. 2023;8(2):79-87. doi: 10.36679/kedokteran.v8i2.15.
Khairiah N, Rahmi N, Miyono. Potensi campuran ekstrak kulit kayu bangkal (Nauclea sp.) dan pegagan (Centella asiatica) sebagai bahan anti jerawat (antiacne). inovasi penelitian pembelajaran biologi. Seminar Nasional Biologi; 2020. p. 2.
Mayasari V, Mahdiyah D, Melviani M. Aktivitas antibakteri akar kayu bangkal (Nauclea subdita) terhadap Staphylococcuc aureus. Innov J Soc Sci Res. 2023;3(6):8074-85.
Listianto Raharjo M, Rahmi N, Khairiah N. Standardisasi ekstrak kulit kayu bangkal (Nauclea subdita) sebagai bahan baku sediaan kosmetika. J Penelitian Hasil Hutan. 2021;39(1).
Priani SE, Nurhasanah E, Suparman A. Development of antiacne nanogel containing cinnamon bark oil (Cinnamomum burmannii Nees ex Bl.) and olive oil (Olea europaea L.). Res J Pharm Technol. 2022;15(1):143-7. doi: 10.52711/0974-360X.2022.00023.
Kotb EA, El Shiekh RA, Hassan M. Potential anti-acne loaded nanogel formulations of Origanum majorana L. and Chrysanthemum morifolium ramat. Essential oils. Appl Biol Chem. 2024;67(1). doi: 10.1186/s13765-024-00859-w.
Tan YY, Wong LS, Nyam KL, Wittayanarakul K, Zawawi NA, Rajendran K. Development and evaluation of topical zinc oxide nanogels formulation using dendrobium anosmum and its effect on acne vulgaris. Molecules. 2023;28(19):6749. doi: 10.3390/molecules28196749, PMID 37836592.
Pereira P, Pedrosa SS, Correia A, Lima CF, Olmedo MP, Gonzalez Fernandez A. Biocompatibility of a self-assembled glycol chitosan nanogel. Toxicol In Vitro. 2015;29(3):638-46. doi: 10.1016/j.tiv.2014.11.004, PMID 25482991.
Zuin VG, Eilks I, Elschami M. Education in green chemistry and in sustainable chemistry: perspectives towards sustainability. Green Chem. 2021;23(4):1594-1608.
Ramadhani S, Elya B, Forestrania RC. Aktivitas anti-elastase dan antioksidan dari ekstrak etanol kayu bangkal (Nauclea subdita) Korth. Steud. dengan variasi metode ekstraksi. Jurnal Mandala Pharmacon Indonesia. 2023;9(2):228-43. doi: 0000-0003-0346-1761.
Masud F, Indriati S, Todingbua A, Rifai A, Sayuti M. Mango seed kernel oil extraction with ethanol: optimization of oil yield and polyphenol. Chem Ind Chem Eng Q. 2021;27(3):207-14. doi: 10.2298/CICEQ200128039M.
Bergeron C, Gafner S, Clausen E, Carrier DJ. Comparison of the chemical composition of extracts from Scutellaria lateriflora using accelerated solvent extraction and supercritical fluid extraction versus standard hot water or 70% ethanol extraction. J Agric Food Chem. 2005;53(8):3076-80. doi: 10.1021/jf048408t, PMID 15826062.
Jafar G, Supriadi D, Alvinda. Formulasi dan evaluasi sediaan mikroemulgel ekstrak daun binahong (anredera cordifolia (ten.) steenis) sebagai antijerawat (staphylococcus aureus). Seminar Nasional Farmasi (SNIFA) UNJANI; 2015;978-602–73.
Sah A, Aggarwal G, Jain GK, Zaidi SM, Naseef PP, Kuruniyan MS. Design and development of a topical nanogel formulation comprising of a Unani medicinal agent for the management of pain. Gels. 2023;9(10):794. doi: 10.3390/gels9100794, PMID 37888367.
YE J, Yang G, Zhang J, Xiao Z, HE L, Zhang H. Preparation and characterization of gelatine polysaccharide composite hydrogels for tissue engineering. Peer J. 2021;9:e11022. doi: 10.7717/peerj.11022, PMID 33777525.
Edityaningrum CA, Kintoko K, Zulien F, Widiyastuti L. Optimization of water fraction gel formula of binahong leaf (Anredera cordifolia (Ten.) Steen) with gelling agent of sodium alginate and carboxymethyl chitosan combination. Majalah Obat Trad. 2018;23(3). doi: 10.22146/mot.36604.
Al Tabakha MM. HPMC capsules: current status and future prospects. J Pharm Pharm Sci. 2010;13(3):428-42. doi: 10.18433/j3k881, PMID 21092714.
Soliman NM, Shakeel F, Haq N, Alanazi FK, Alshehri S, Bayomi M. Development and optimization of ciprofloxacin HCl-loaded chitosan nanoparticles using box behnken experimental design. Molecules. 2022;27(14):4468. doi: 10.3390/molecules27144468, PMID 35889340.
Erwin E. Physical evaluation of manalagi apple extract mouthwash. Sanitas. 2022;13(2):245-55. doi: 10.36525/sanitas.2022.21.
Hayat M, Nawaz A, Chinnam S, Muzammal M, Latif MS, Yasin M. Formulation development and optimization of herbo synthetic gel: in vitro biological evaluation and in vivo wound healing studies. Process Biochem. 2023;130:116-26. doi: 10.1016/j.procbio.2023.04.010.
Ali A, Ali A, Rahman MA, Warsi MH, Yusuf M, Alam P. Development of nanogel loaded with lidocaine for wound healing: illustration of improved drug deposition and skin safety analysis. Gels. 2022;8(8):466. doi: 10.3390/gels8080466, PMID 35892725.
Sanganabhatla D, Sunder RS. A novel nanogel formulation of finasteride for topical treatment of androgenetic alopecia: design characterization and in vitro evaluation. Int J Appl Pharm. 2021;13(4):228-40. doi: 10.22159/ijap.2021v13i4.41599.
Zothanpuii F, Rajesh R, Selvakumar K. A review on stability testing guidelines of pharmaceutical products. Asian J Pharm Clin Res. 2020. doi: 10.22159/ajpcr.2020.v13i10.38848.
Akullo JO, Kiage B, Nakimbugwe D, Kinyuru J. Effect of aqueous and organic solvent extraction on in vitro antimicrobial activity of two varieties of fresh ginger (Zingiber officinale) and garlic (Allium sativum). Heliyon. 2022;8(9):e10457. doi: 10.1016/j.heliyon.2022.e10457, PMID 36091965.
Jahangirian H, Haron J, Shah MH. Well diffusion method for evaluation of an antibacterial activity. Dig J Nanomater Biostruct. 2013;8(3):1263-70.
Zeng L, MA M, LI C. Stability of tea polyphenols solution with different pH at different temperatures. Int J Food Prop. 2017;20(1):1-18. doi: 10.1080/10942912.2014.983605.
Kurniawan DW, Agustina VN, Sunarto. Formulation of cinnamon bark essential oil gel as mosquito repellent. Int J Appl Pharm. 2022;14(1):208-12. doi: 10.22159/ijap.2022v14i1.43034.
Wada NM, Ambi AA, Ibrahim AA. Antimicrobial activity of extracts of turmeric (Curcuma longa) and garlic (Aliium sativum) against selected bacterial clinical isolates. Mediterr J Infect Microbes Antimicrob. 2021;10:6. doi: 10.4274/mjima.galenos.2021.2020.6.
Listianto Y, Sari R, Triyasmono S. Antibacterial activity of bangkal bark extract against propionibacterium acnes. J Farmasi Sains Terapan. 2021.
AL Samman MT, Sanchez J. Chitosan and alginate-based hydrogels for the adsorption of anionic and cationic dyes from water. Polymers (Basel). 2022;14(8):1498. doi: 10.3390/polym14081498, PMID 35458248.
Wathoni N, Suhandi C, Ghassani Purnama MF, Mutmainnah A, Nurbaniyah NS, Syafra DW. Alginate and chitosan-based hydrogel enhance antibacterial agent activity on topical application. Infect Drug Resist. 2024;17:791-805. doi: 10.2147/IDR.S456403, PMID 38444772.